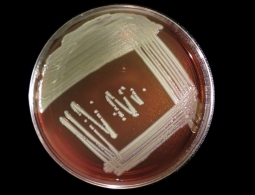
Бактерия, считавшаяся безвредной, вызвала смертельную инфекцию

Популярные новости
Не пропустите выставку «Витражи творчества» фотоху...
16 октября в 15:00 состоится торжественное открытие выставки «Витражи творчества» фотохудожника, члена Союза фотохудожников РФ Юхмана Виктора Георгиевича в МБУК «Городской выставочный зал» по адресу: бульвар Гагарина, д.19.На выставке представлены «виражи» сорокалетнего непрерывного творчества автора в живописи, художественной, документальной, рекламной, бытовой, видовой фотографии, компьютерной графике, затрагивающие жанры пейзажа, портрета, натюрморта, ж...
Власти США объявят о новых мерах по нераспространению ядерного оружия
МОСКВА, 25 июн — РИА Новости. Администрация президента США Барака Обамы объявит о новых мерах по нераспространению оружия массового поражения до завершения его президентского срока в январе 2017 года, сообщил
СМИ: Пентагон объявит о снятии запрета на службу трансгендеров в армии США
МОСКВА, 25 июн — РИА Новости. Пентагон 1 июля планирует объявить о снятии запрета на службу в войсках США трансгендеров, сообщила газета
В Чили произошло землетрясение магнитудой 5,5
МОСКВА, 25 июн — РИА Новости. Землетрясение магнитудой 5,5 произошло в Чили, сообщает Геологическая служба США (USGS).Подземные толчки были зафиксированы в пятницу в 21.29 по времени UTC (00.29 в субботу мск). Эпицентр располагался в 73 километрах к северо-востоку от города Диего де Альмагро....
В Белоруссии сообщили о похоронах уроженца Гродно, служившего в ВС РФ
МИНСК, 25 июня — РИА Новости. Белорусское военное ведомство подтверждает сообщения о похоронах в Гродно российского военнослужащего, уроженца Белоруссии.Ранее о факте похорон сообщили белорусские СМИ. При этом польский телеканал
В Западной Вирджинии число погибших из-за наводнения достигло 18 человек
МОСКВА, 25 июн — РИА Новости. Число погибших из-за наводнения в американском штате Западная Вирджиния достигло 18 человек, сообщило агентство
Дейсселблум: Brexit ограничит доступ фининститутов Британии к рынку ЕС
МОСКВА, 25 июн — РИА Новости. Глава Еврогруппы Йерун Дейсселблум завил, что выход Великобритании из Европейского Союза ограничит доступ британских финансовых институтов к внутреннему европейскому рынку, сообщило
Обама сожалеет о предстоящей отставке Кэмерона
ВАШИНГТОН, 25 июн – РИА Новости. Президент США Барак Обама в пятницу в ходе телефонного разговора с премьер-министром Великобритании Дэвидом Кэмероном выразил сожаление в связи с его планами уйти в отставку, сообщает Белый дом.>В четверг в Великобритании прошел референдум по членству страны в...
Президент Эквадора прокомментировал выход Британии из ЕС
МЕХИКО, 24 июн – РИА Новости. Возможный выход Великобритании из ЕС может ослабить евро, что представляет опасность для Эквадора, заявил в пятницу президент южноамериканской страны Рафаэль Корреа.>В четверг в Великобритании прошел референдум по членству страны в ЕС. Согласно официальным данным,...
СМИ: в Калифорнии из-за пожаров погибли два человека
МОСКВА, 24 июн — РИА Новости. По меньшей мере два человека погибли в результате пожаров в американском штате Калифорния, сообщили местные власти.Пожары охватили горные районы в центре штата. Капитан пожарной службы округа Керн Тайлер Таунсенд сказал местному телеканалу KBAK-TV, что тела погибш...
Белорусы прислушались к совету Лукашенко "раздеваться и работать"
МОСКВА, 24 июн – РИА Новости. Пользователи сети в Белоруссии участвуют во флешмобе под хештегом
В Мексике в ДТП с автобусом погибли десять человек, 29 получили ранения
МЕХИКО, 24 июн – РИА Новости. ДТП с участием автобуса в Мексике унесло жизни 10 человек, 29 получили ранения, сообщают в пятницу власти штата Чиуауа.По данным полиции, рано утром автобус врезался в трейлер на дороге по направлению к городу Сьюдад-Хуарес, отмечает El Sol de Mexico.На месте траг...
Бактерия, считавшаяся безвредной, вызвала смертельную инфекцию
Смертельная инфекция, распространившаяся в трех штатах, озадачила ученых в США. Болезнь вызывает бактерия Elizabethkingia Anopheles, которая обитает в воде и почве. До сих пор этот микроорганизм не создавал никаких проблем. Впервые об инфекционной вспышке сообщили органы общественного здравоохранен...